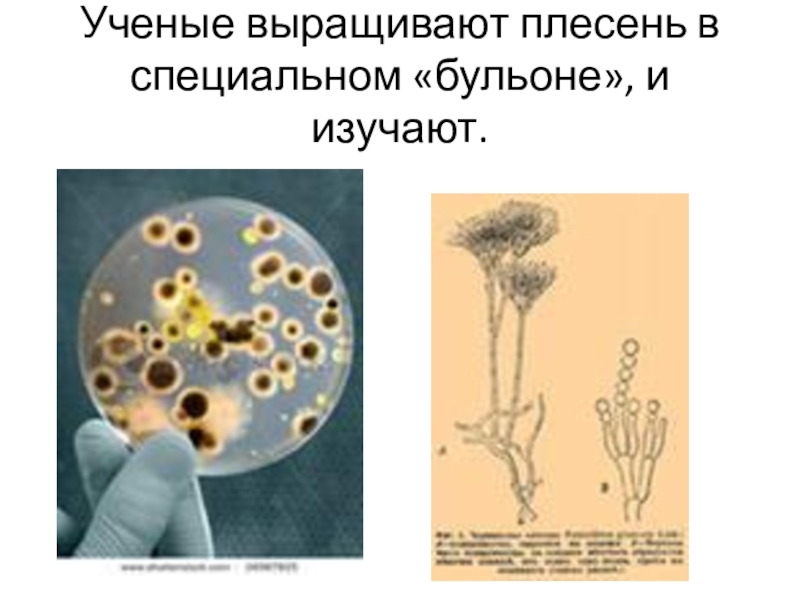

Зинаида Петровна
- Главная
- Разное
- Образование
- Спорт
- Естествознание
- Природоведение
- Религиоведение
- Французский язык
- Черчение
- Английский язык
- Астрономия
- Алгебра
- Биология
- География
- Геометрия
- Детские презентации
- Информатика
- История
- Литература
- Математика
- Музыка
- МХК
- Немецкий язык
- ОБЖ
- Обществознание
- Окружающий мир
- Педагогика
- Русский язык
- Технология
- Физика
- Философия
- Химия
- Шаблоны, фоны, картинки для презентаций
- Экология
- Экономика
Презентация, доклад Плесень – что это такое Работа Бурмакиной Ирины, Ученицы 2 А класса Руководитель Морозова Зинаида Петровна
Содержание
- 1. Презентация Плесень – что это такое Работа Бурмакиной Ирины, Ученицы 2 А класса Руководитель Морозова Зинаида Петровна
- 2. План Что такое плесень?Изучение плесени учеными.Благоприятные условия
- 3. Исследование
- 4. Ученые выращивают плесень в специальном «бульоне», и изучают.
- 5. Вот такая плесень под микроскопом
- 6. Что такое плесеньПлесень принадлежит к классу грибов.
- 7. Что такое плесень Она поражает все (
- 8. Цвет плесениЦвет разный: серый, желтый, красный, черный,
- 9. Разные виды плесени
- 10. Идеальные условия для неё 1. Грязь. 2. Тепло -
- 11. Вред плесени 1. Болезни у людей. Если не проветривать
- 12. Плесень в доме – путь к болезням!
- 13. Это причина болезней растений
- 14. Самая опасная плесеньНаиболее опасна черная плесень (при
- 15. Плесень – токсична! Плесень – яд! Заплесневелые
- 16. Такое варенье надо выкинуть! (Даже если перекипятить, токсины останутся!)
- 17. Как бороться с плесенью Хлеб. Защищаем его
- 18. Защита жилища1. Отапливать дом.Проветривать дом. 3. «Пускать»
- 19. Испорченные продукты плесень, которая появляется на еде
- 20. Плесень – яд!
- 21. Зерно может быть поражено спорыньей. Беда, если его употребить в пищу.
- 22. Спорынья При употреблении в пищу продуктов из
- 23. Другое название – черное зерно, волчье зерно.
- 24. «Проклятие фараона»
- 25. «Каждого, кто проникнет в гробницу с нечистыми
- 26. Проклятие фараона Тутанхамона После того, как в 1922
- 27. Польза от плесениС её помощью делают сыр.
- 28. Александр Флеминг – создатель 1 антибиотика – пенициллина.
- 29. Польза от плесени – сыр.
- 30. ВыводПлесень вездесуща и неистребимаОна убивает и спасает.Плесень
- 31. Она бывает удивительно красива!
- 32. Различна по окраске
- 33. Споры плесени выжили в космосе (при опыте на МКС)
- 34. Споры у некоторых плесневых грибков созревают как у настоящих грибов – под шляпкой
- 35. Мы знаем о ней не всё
- 36. Она сказочно красива!
- 37. Ей не страшна радиация!
- 38. Плесень плохо изучена
- 39. Вопросы по теме:1.Чем размножается плесень?2. Какие условия
- 40. Спасибо за внимание!
План Что такое плесень?Изучение плесени учеными.Благоприятные условия для плесени.Какой она бывает.Вред от плесени (болезни, отравления спорыньей, разрушения материалов ).Польза от плесени (сыр, вино, лекарства).Как бороться с плесенью.
Слайд 2План
Что такое плесень?
Изучение плесени учеными.
Благоприятные условия для плесени.
Какой она бывает.
Вред от
плесени (болезни, отравления спорыньей, разрушения материалов ).
Польза от плесени (сыр, вино, лекарства).
Как бороться с плесенью.
Польза от плесени (сыр, вино, лекарства).
Как бороться с плесенью.
Слайд 3 Исследование плесени микробиологами
Появилась задолго
до появления человека.
Даже сегодня плесень остается одной из самых загадочных форм жизни.
Даже сегодня плесень остается одной из самых загадочных форм жизни.
Слайд 6Что такое плесень
Плесень принадлежит к классу грибов.
Плесень и ее споры
могут быть везде.
Некоторые виды плесени активны летом и осенью , а другие – образуют споры круглый год .
Некоторые виды плесени активны летом и осенью , а другие – образуют споры круглый год .
Слайд 7Что такое плесень
Она поражает все ( бетон, дерево, резину, пластик,
окрашенные стены, бумагу, ткани пищу и т.д.).
Слайд 8Цвет плесени
Цвет разный: серый, желтый, красный, черный, бурый, голубой, зеленый.
На Кавказе, глубоко под землей, в пещерах обнаружена плесень, которая светится
(причем свечение настолько явное, что на расстоянии полуметра можно различить черты лица человека).
(причем свечение настолько явное, что на расстоянии полуметра можно различить черты лица человека).
Слайд 10Идеальные условия для неё
1. Грязь.
2. Тепло - (+20 по Цельсию),
3. Плохая
вентиляция
4. Влажность. Грибок просто обожает влагу.
При холоде она «замирает».
При жаре гибнет.
(хотя есть такие виды плесневых грибков, на которые надо воздействовать 100-градусной температурой в течение одного - двух часов, чтобы убить их)
4. Влажность. Грибок просто обожает влагу.
При холоде она «замирает».
При жаре гибнет.
(хотя есть такие виды плесневых грибков, на которые надо воздействовать 100-градусной температурой в течение одного - двух часов, чтобы убить их)
Слайд 11Вред плесени
1. Болезни у людей.
Если не проветривать помещение, споры плесени попадают
нам в легкие .
Доказано, что плесень способна вызывать аллергию, переходящую в астму.
Споры плесени способствуют многим другим заболеваниям.
2. Болезни растений.
3. Разрушение строительных и др. материалов.
Доказано, что плесень способна вызывать аллергию, переходящую в астму.
Споры плесени способствуют многим другим заболеваниям.
2. Болезни растений.
3. Разрушение строительных и др. материалов.
Слайд 14Самая опасная плесень
Наиболее опасна черная плесень (при дыхании).
(Пятно нужно сначала
тщательно смыть спец. раствором, а потом уже сушить опасное место, иначе споры разлетятся).
На пище наиболее опасным видом является плесень желтого цвета .
( Яд, который содержит подобная плесень, способен при накоплении вызвать рак печени!).
На пище наиболее опасным видом является плесень желтого цвета .
( Яд, который содержит подобная плесень, способен при накоплении вызвать рак печени!).
Слайд 15Плесень – токсична!
Плесень – яд! Заплесневелые продукты – выкидывайте без
сожаления. Не исключение и бабушкино варенье!
Нити грибницы плесени пронизывают всё. Даже если плесень видна с одного бочка фрукта или хлеба, она во всех частях продукта. Просто это не видно не вооруженным глазом. И не надейтесь, что, обрезав плесень, хлебушек можно еще скушать.
Нити грибницы плесени пронизывают всё. Даже если плесень видна с одного бочка фрукта или хлеба, она во всех частях продукта. Просто это не видно не вооруженным глазом. И не надейтесь, что, обрезав плесень, хлебушек можно еще скушать.
Слайд 17Как бороться с плесенью
Хлеб. Защищаем его следующим образом. Берем ватный
тампон, капаем на него 5-7 капель йода, кладем в стеклянный чистый пузырек или пробирку, затыкаем чистым ватным тампоном и в пакет с хлебом. Пакет плотно завязываем. В таком состоянии хлеб может существовать неделю – плесень ему не страшна!
Или хранить в холодильнике.
Если надо долго хранить – делать сухари.
Или хранить в холодильнике.
Если надо долго хранить – делать сухари.
Слайд 18Защита жилища
1. Отапливать дом.
Проветривать дом.
3. «Пускать» солнце в дом. Солнечные
лучи также обеззараживают!
4. Вовремя съедать продукты, вовремя менять фильтры в кондиционерах и очистителях воды.
5. Использовать спец. химические средства.
4. Вовремя съедать продукты, вовремя менять фильтры в кондиционерах и очистителях воды.
5. Использовать спец. химические средства.
Слайд 19Испорченные продукты
плесень, которая появляется на еде без нашего участия не
содержит пенициллина и не имеет никаких полезных свойств.
Слайд 22Спорынья
При употреблении в пищу продуктов из такого зерна (пораженного спорыньей)
происходит отравление. Возникают рвота, слюнотечение, сильная головная боль.
Слайд 25«Каждого, кто проникнет в гробницу с нечистыми помыслами , я окольцую,
словно птицу»
Надпись на могиле с мумией Тутанхамона
Слайд 26Проклятие фараона Тутанхамона
После того, как в 1922 была найдена и вскрыта
гробница фараона, большая часть членов команды погибли . Причины их смерти не установлены.
В 1999 г. Немецкий ученый обнаружил, что мумии покрыты слоем плесени (это было видно только вооруженным глазом).
Слайд 27Польза от плесени
С её помощью делают сыр. Это специальная плесень, которую
«вносят» в сыр.
Вино. При производстве некоторых видов вин используют специальные плесневые грибы.
С помощью плесени создано лекарство – пенициллин – первый антибиотик, спасший миллионы жизней.
Вино. При производстве некоторых видов вин используют специальные плесневые грибы.
С помощью плесени создано лекарство – пенициллин – первый антибиотик, спасший миллионы жизней.
Слайд 30Вывод
Плесень вездесуща и неистребима
Она убивает и спасает.
Плесень хорошая и плохая.
Её не
стоит бояться, надо просто знать о ней и защищать себя. «Чистота – залог здоровья».
Слайд 39Вопросы по теме:
1.Чем размножается плесень?
2. Какие условия благоприятны для развития плесени?(грязь,
тепло, плохая вентиляция, влажность).
3. Какой вред от плесени? (болезни и разрушения материалов).
4. Польза от плесени? (делают сыр, вино, лекарство).
5. Как фамилия ученого микробиолога, создавшего первый антибиотик – пенициллин? (Александр Флеминг).
6. Как называется плесневый грибок, поражающий зерно? (Спорынья).
7. Как еще называют пораженное зерно? (Черное, волчье зерно).
3. Какой вред от плесени? (болезни и разрушения материалов).
4. Польза от плесени? (делают сыр, вино, лекарство).
5. Как фамилия ученого микробиолога, создавшего первый антибиотик – пенициллин? (Александр Флеминг).
6. Как называется плесневый грибок, поражающий зерно? (Спорынья).
7. Как еще называют пораженное зерно? (Черное, волчье зерно).